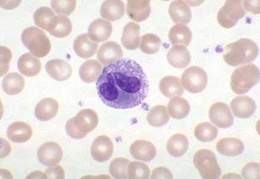
O que são Eosinófilos e sua Função no Corpo
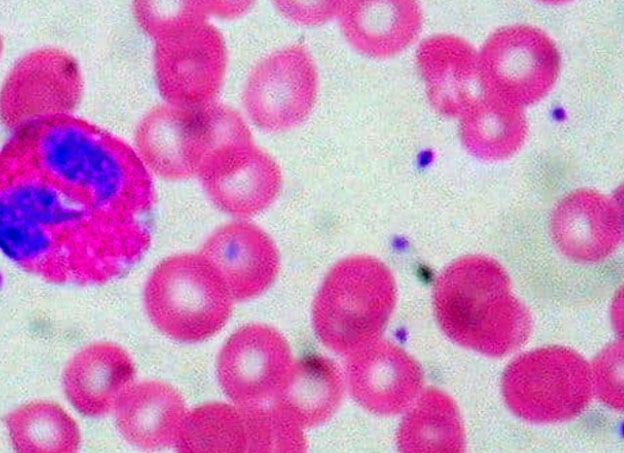
Guia Completo sobre Alergias e Eosinofilia

Você já ouviu falar sobre eosinófilos, mas não tem certeza do que eles significam nos seus exames? Pois é, esses glóbulos brancos são importantes pistas para a saúde do seu corpo. Muitas vezes, níveis alterados podem indicar reações a algo que seu sistema imune está combatendo, como alergias ou infecções. Neste post, eu vou desmistificar o mundo dos eosinófilos para você entender de uma vez por todas o que seus exames podem estar dizendo. Vamos desvendar esses números juntos e trazer mais clareza para sua saúde!
Eosinófilos Altos e Baixos: O Que Eles Revelam Sobre Seu Sistema Imunológico em 2026?
Quando seus eosinófilos estão altos, é um sinal claro de que seu corpo está em alerta. Ele indica que o sistema imunológico está trabalhando para combater algo específico.
A razão mais comum para essa elevação são as alergias. Pense em rinite, asma ou até aquela urticária chata – os eosinófilos estão envolvidos.
Infestações por parasitas também são um gatilho frequente para o aumento desses glóbulos brancos.
Além disso, reações a certos medicamentos podem fazer seus níveis subirem.
Em situações menos comuns, eosinófilos persistentemente altos podem apontar para doenças autoimunes ou, raramente, para alguns tipos de câncer.
Por outro lado, ter eosinófilos baixos, ou eosinopenia, nem sempre é motivo de preocupação isolada. Afinal, o valor mínimo de referência pode ser até zero.
Isso pode acontecer se você estiver usando corticoides, passando por estresse físico extremo ou em infecções bacterianas agudas, como a sepse. Nesses casos, as células tendem a migrar rapidamente para os tecidos afetados.
“Valores normais de eosinófilos variam entre 1% a 5% do total de leucócitos, ou uma contagem absoluta de 50 a 500 células por microlitro (µL).”

Eosinófilos: O Que São e Por Que Importam no Seu Hemograma
No universo dos exames de sangue, cada célula conta uma história sobre o que está acontecendo dentro do seu corpo. Os eosinófilos são um tipo específico de glóbulo branco, parte essencial do seu sistema imunológico. Eles atuam como verdadeiros sentinelas, prontos para identificar e combater invasores, especialmente aqueles que não são bactérias, como parasitas, e também em reações alérgicas.
Entender seus níveis no hemograma é fundamental. Uma contagem fora do comum pode ser um sinal precoce de que algo precisa de atenção. Não se trata apenas de um número em um papel; é uma pista valiosa que, quando interpretada corretamente por um profissional de saúde, ajuda a direcionar diagnósticos e tratamentos de forma eficaz.
| Característica | Função Principal | Onde Atua |
|---|---|---|
| Tipo de Glóbulo Branco | Defesa Imunológica | Sangue e Tecidos |
| Principal Alvo | Parasitas e Alergias | Vias Aéreas, Pele, Trato Digestivo |
| Alterações Comuns | Eosinofilia (Alto), Eosinopenia (Baixo) | Indicam Processos Inflamatórios/Infecciosos |

O que são Eosinófilos?
Os eosinófilos são um dos cinco tipos de leucócitos (glóbulos brancos) presentes no nosso sangue. Eles são produzidos na medula óssea e, após amadurecerem, circulam pelo corpo. Sua principal função é combater infecções causadas por parasitas, como vermes, e modular as respostas inflamatórias em reações alérgicas.
Suas granulações, visíveis ao microscópio, contêm substâncias químicas poderosas que ajudam a destruir patógenos. Quando o corpo detecta a presença de parasitas ou inicia uma resposta alérgica, a produção e a migração de eosinófilos para a área afetada aumentam significativamente.

Eosinófilos Altos (Eosinofilia)
Um aumento na contagem de eosinófilos, conhecido como eosinofilia, geralmente indica que o seu sistema imunológico está ativamente combatendo algo. As causas mais frequentes incluem condições alérgicas, como rinite, asma e urticária, além de infestações por parasitas. Reações adversas a medicamentos também figuram entre os motivos comuns.
Em situações menos comuns, mas que exigem investigação, a eosinofilia persistente pode estar associada a doenças autoimunes ou a certos tipos de câncer. Por isso, é crucial não ignorar esse achado e buscar a avaliação de um médico.

Eosinófilos Baixos (Eosinopenia)
A eosinopenia, ou a baixa contagem de eosinófilos, frequentemente não representa um problema isolado, pois o valor de referência inferior em muitos laboratórios pode ser zero. Essa redução pode ocorrer em resposta ao uso de corticoides, que suprimem a liberação de eosinófilos na corrente sanguínea.
Situações de estresse físico intenso ou infecções bacterianas agudas, como a sepse, também podem levar à eosinopenia. Nesses casos, os eosinófilos tendem a migrar rapidamente dos vasos sanguíneos para os tecidos inflamados, diminuindo sua contagem no sangue periférico.

Valores de Referência de Eosinófilos
Os valores considerados normais para eosinófilos podem variar ligeiramente entre laboratórios, mas geralmente se situam em uma faixa específica. A contagem absoluta é mais informativa e costuma variar entre 50 a 500 células por microlitro (µL) de sangue. Em termos percentuais, representam tipicamente de 1% a 5% do total de leucócitos.
É importante lembrar que esses são valores de referência. O que é normal para uma pessoa pode não ser para outra, dependendo de diversos fatores. A interpretação deve sempre considerar o quadro clínico completo.

Causas Comuns de Eosinofilia
As alergias são, sem dúvida, as protagonistas quando falamos de eosinofilia. Condições como rinite alérgica, asma e urticária frequentemente elevam os níveis de eosinófilos, pois essas células são recrutadas para mediar a resposta inflamatória alérgica. Parasitoses intestinais ou de outros órgãos também são causas muito relevantes, especialmente em certas regiões geográficas.
Além disso, muitas medicações podem desencadear uma resposta eosinofílica como efeito colateral. É essencial que o médico saiba de todos os medicamentos que você está utilizando para avaliar essa possibilidade.
Causas de Eosinopenia
A eosinopenia é mais comumente observada em situações de estresse agudo para o organismo. O uso de corticosteroides, sejam eles orais, injetáveis ou mesmo tópicos em altas doses, é um dos principais motivos para a diminuição dos eosinófilos no sangue. Isso ocorre porque os corticoides inibem a liberação dessas células da medula óssea e promovem sua saída da circulação.
Infecções bacterianas graves, como a sepse, também podem levar à eosinopenia. Nesses cenários, o corpo prioriza a resposta a outras células de defesa, e os eosinófilos podem ser direcionados para os focos de infecção nos tecidos, resultando em uma contagem baixa no sangue periférico.
Importância da Interpretação Médica
Vamos combinar: nenhum exame isolado é uma sentença. A interpretação dos níveis de eosinófilos deve ser sempre feita por um médico. Ele analisará seu hemograma completo, levando em conta não apenas a contagem de eosinófilos, mas também os outros componentes do seu sangue, e cruzará essas informações com seus sintomas e histórico clínico.
Essa abordagem integrada é a única maneira de chegar a um diagnóstico preciso. Um valor alterado, seja alto ou baixo, é um ponto de partida para a investigação, não uma conclusão em si.

Sintomas Associados a Alterações nos Eosinófilos
Os sintomas que acompanham alterações nos níveis de eosinófilos dependem diretamente da causa subjacente. Na eosinofilia associada a alergias, você pode notar espirros frequentes, coriza, coceira nos olhos, tosse, chiado no peito ou erupções cutâneas. Em infestações parasitárias, podem surgir dores abdominais, diarreia, náuseas ou perda de peso.
Já a eosinopenia, por si só, raramente causa sintomas diretos, pois está mais ligada a uma resposta do corpo a um estresse ou condição específica. Os sintomas que você sentir serão, na verdade, os da condição que está levando à redução dos eosinófilos, como os de uma infecção bacteriana grave ou os efeitos colaterais de um medicamento.

Vale a Pena Investigar Seus Eosinófilos?
Com certeza! Seus eosinófilos são indicadores valiosos da sua saúde. Uma contagem alterada, especialmente a eosinofilia, é um sinal que seu corpo envia para alertar sobre processos inflamatórios, alérgicos ou infecciosos que podem estar passando despercebidos ou que merecem atenção especializada.
Não encare seu exame de sangue como um simples relatório burocrático. Veja-o como uma ferramenta poderosa de autoconhecimento e prevenção. Ao discutir os resultados com seu médico, você abre portas para diagnósticos mais rápidos e tratamentos mais direcionados, garantindo que seu sistema imunológico esteja funcionando em harmonia para proteger você.
Este conteúdo é informativo, consulte um especialista.
Dicas Extras
- Fique atenta aos detalhes: A contagem de eosinófilos é apenas uma peça do quebra-cabeça. Seu médico vai analisar esse número junto com outros resultados do seu hemograma e seu histórico clínico.
- Observe seu corpo: Sintomas como coceira persistente, espirros frequentes, tosse ou erupções na pele podem estar ligados a alterações nos eosinófilos. Anote tudo para conversar com seu médico.
- Cuidado com automedicação: Alguns medicamentos, especialmente corticoides, podem alterar seus níveis de eosinófilos. Sempre use remédios sob orientação profissional.
- Estilo de vida importa: Estresse físico intenso, como após uma cirurgia ou infecção grave, pode temporariamente afetar a contagem. O corpo tem suas formas de reagir.
Dúvidas Frequentes
O que significa ter eosinófilos altos?
Eosinófilos altos, ou eosinofilia, geralmente indicam que seu corpo está reagindo a algo. As causas mais comuns são alergias, como rinite ou asma, e infestações por parasitas. Em alguns casos, pode estar relacionado a reações a medicamentos ou, mais raramente, a doenças autoimunes.
Eosinófilos baixos são perigosos?
Ter eosinófilos baixos, ou eosinopenia, nem sempre é um sinal de alerta. Frequentemente, o valor de referência inferior é zero. Isso pode acontecer com o uso de corticoides, em situações de estresse físico intenso ou infecções bacterianas agudas, pois as células se deslocam para os tecidos afetados.
Qual a contagem normal de eosinófilos?
Normalmente, os eosinófilos representam de 1% a 5% do total de leucócitos (glóbulos brancos) no seu sangue. Em termos de contagem absoluta, o valor de referência costuma ficar entre 50 a 500 células por microlitro (µL). Lembre-se que a interpretação deve ser feita pelo seu médico.
Conclusão
Entender os níveis de eosinófilos é um passo importante para cuidar da sua saúde. Lembre-se que esses números são indicativos e precisam ser interpretados por um profissional. Se você tem dúvidas sobre alergias ou o papel dos eosinófilos em doenças autoimunes, converse com seu médico. Ele é a melhor pessoa para guiar você.

